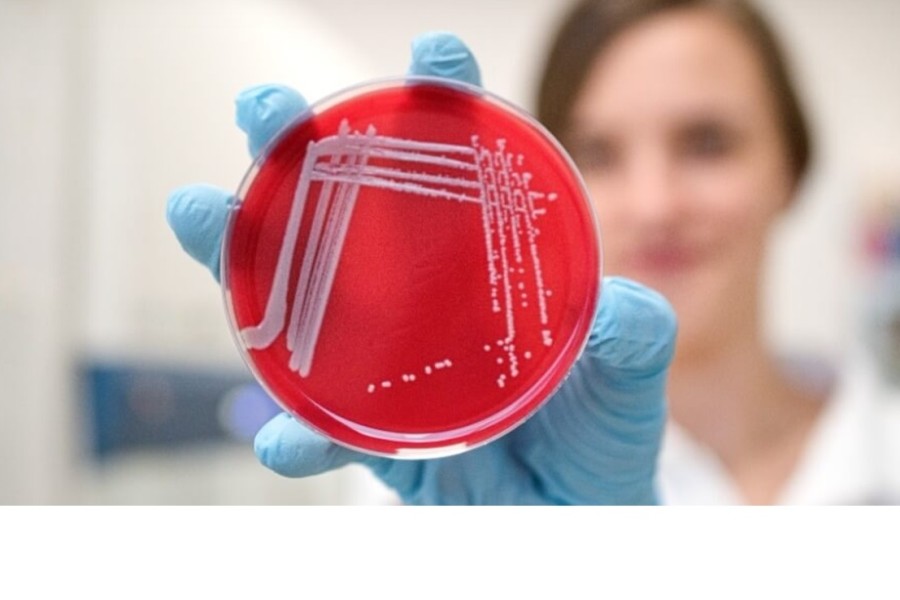

Molekulární biolog Dalibor Blažek z institutu CEITEC Masarykovy univerzity letos obdržel Cenu předsedy GA ČR za výzkum cyklin-dependentních kináz.
- Základní údaje
- CEITEC MUNI
- Věda

Molekulární biolog Dalibor Blažek z institutu CEITEC Masarykovy univerzity letos obdržel Cenu předsedy GA ČR za výzkum cyklin-dependentních kináz.

Asi 50 km východně od Nilu v dnes extrémně suché oblasti centrálního Súdánu objevili čeští vědci zaniklé vodní prameny a u některých z nich důkazy o lidském osídlení. Geoarcheologický průzkum a jeho výsledky rekonstruují klimatické změny ve východním Sahelu během posledních 30 000 let.

V ortopedii je třeba někdy kost zafixovat kovovými šrouby, destičkami či dráty a po čase je zase operativně odebrat. Co kdyby se místo toho v těle prostě rozpustily?

Přinášíme přehled nejsdílenějších vědeckých článků na sociálních sítích za listopad. Co se z něj dozvíte? Že mozek má v sobě mikroorganismy, že resuscitaci bychom se měli učit i na ženských figurínách, že mladé Američanky umírají méně na rakovinu děložního čípku díky očkování proti HPV nebo že příznaky ADHD jsou mírnější při nabitém harmonogramu.

Vědci z Fyzikálního ústavu Akademie věd ČR zveřejnili v časopise Nature první přímé mikroskopické snímky magnetického uspořádání v altermagnetu. Navazují tak na publikaci z počátku roku, kdy v časopise Nature oznámili objev nové větve magnetické rodiny, označované jako altermagnetická. Mikroskopické snímky představují milník, na nějž naváže další experimentální výzkum.

Mladý vědec z Ústavu biomedicínského inženýrství Fakulty elektrotechniky a komunikačních technologií (FEKT) získal prestižní grant. Karel Sedlář se zařadil mezi elitní skupinu 19 mladých výzkumníků, kterým Grantová agentura České republiky (GA ČR) udělila podporu v programu JUNIOR STAR. V následujících pěti letech bude moci svůj výzkumný projekt financovat částkou 25 milionů korun.

Vědci z Botanického ústavu Akademie věd ČR, ve spolupráci s dalšími výzkumnými institucemi, odhalili původ mimořádné druhové bohatosti luk v rumunské Transylvánii, které patří mezi nejbohatší na světě.
Zemědělci před dvěma dekádami přestali využívat antibiotika v chovech hospodářských zvířat a nahradili je zinkem. Tehdy se předpokládalo, že tento krok bude k životnímu prostředí s ohledem na rozvoj antimikrobiální rezistence šetrnější. Výzkum odborníků z Ústavu chemie a biochemie AF Mendelovy univerzity v Brně ale prokázal, že výraznější změnu nepřinesl.

Velkého úspěchu dosáhli vědci a vědkyně UK. Pětici z nich se podařilo získat prestižní ERC Consolidator grant. To je nebývalý úspěch nejen pro samotné badatele, ale pro celou Českou republiku, která ve srovnání s ostatními státy evropské sedmadvacítky dosud nepatřila zrovna k nejúspěšnějším v získávání prestižních grantů Evropské výzkumné rady.

Vitamin E acetát a některé další látky obsažené v liquidech e-cigaret deformují a oslabují ochrannou lipidovou vrstvu uvnitř plic. Zjistili to vědci z Ústavu fyzikální chemie J. Heyrovského AV ČR ve spolupráci s Helsinskou univerzitou. Studii vydal časopis Scientific reports v nakladatelství Nature.